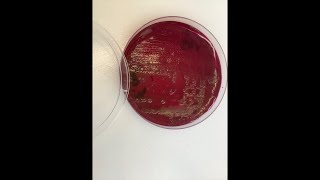

Кишечная палочка — Escherichia coli (E. coli). Методы лабораторной диагностики (посев, определение)
Similar Tracks
Проблема плесневых грибков в жилых помещениях. Отвечаю на вопросы. К.б.н. Роман Овчинников, 2023.
Микробиология и инфекции. Канал Романа Овчинникова
Elon Musk's Family History in South Africa Reveals Ties to Apartheid & Neo-Nazi Movements
Democracy Now!
Soothing ,Restores The Nervous System🌿Stop Overthinking, Stress Relief Music, Sleep Music #19
Melody Peaks
Уролог Кубин Н.Д.: Лечение инфекции нижних мочевых путей: стандарты, возможности и реальность
Образовательный центр «Интернет Лид»